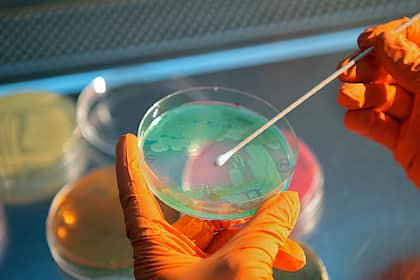
Kurspotenzial im SPI: Schweizer Aktien im Analystencheck Ein Basilea-Mitarbeiter entnimmt im Labor eine Probe.

- Home
- Nachhaltigkeit mit unterschiedlichen Risikoprofilen
Nachhaltigkeit mit unterschiedlichen Risikoprofilen
Wer nachhaltig breit investieren will, kommt an Themenfonds nicht herum. Die Bereiche Wasser und Klima bieten zwei verschiedene Wege und Risikoprofile.